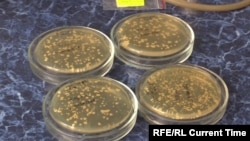
Ученые Львовского Института клетки разработали необычный препарат от коронавируса

Ученые Львовского Института клетки разработали необычный препарат от коронавируса, который планируют выпускать в виде спрея или таблеток. Он создан на основе высушенных клеток... дрожжей, к которым ученые прикрепляют небольшую часть вируса в виде суспензии сухих клеток.
"Она [вакцина] в порошке, потому что это клетки, на поверхности которых есть мобилизованные фрагменты с–шипа вируса, который вызывает COVID-19", – достает пробирки из холодильника старший научный сотрудник Константин Дмитрук, замдиректора Института биологии клетки Национальной академии наук Украины во Львове. Белый порошок – это и есть высушенные клетки дрожжей. К ним ученые прикрепляют небольшую часть вируса.
"Эти клетки экспрессируются на поверхности клеток дрожжей, соответственно, не требуется разрушать клетку, извлекать этот белок, его очищать. То есть, это получается условно суспензия сухих клеток", – объясняет Анастасия Зазуля, инженер Института биологи клетки во Львове.
Скоро вакцину протестируют на специально выведенных лабораторных мышах, которых заразят ковидом. В Украине ни у одной компании еще нет разрешения на такие лабораторные эксперименты с вирусом, поэтому исследование проведут в Польше. Если эксперимент удастся – препарат начнут производить, но это произойдет не раньше, чем через полгода.
"Если антитела будут образовываться, значит вакцина в какой-то степени работает. И тогда мы можем дальше испытывать препарат, возможно уже на людях или дальше на каких-то крупных животных", — говорит Олена Дмитрук, научный сотрудник Института биологии клетки.
Похожие вакцины от ковида в виде порошка разрабатывают в Швеции, Китае, России, США. Но львовские ученые считают главным достоинством своего препарата то, что он дешев в производстве.
"Безусловное преимущество вакцины такого типа на основе клеток, клеток дрожжей — это дешевое ее производство, — подчеркивает Константин Дмитрук. — Фактически, для того чтобы получить в большом количестве такую вакцину, нам необходимо вырастить только клетки дрожжей. А для этого можно использовать обычные колбы".
"Для Украины это имеет огромное значение. Мы тогда сможем легко наладить промышленное производство собственной украинской вакцины, что имеет стратегическое значение для биобезопасности вообще, для безопасности государства и безопасности людей", — отдельно замечает Андрей Сыбирный, директор Института биологи клетки.
В Украине сегодня поставлено уже достаточное число вакцин от коронавируса. И часть ученых считает, что разработка львовских ученых стране не нужна: нужно прививать уже имеющимися препаратами, которые показали свою действенность.
"Нужна ли сейчас новая вакцина против коронавируса? Я думаю, что нет, — говорит академик Сергей Комисаренко, директор Института биохимии О. В Палладина Национальной академии наук Украины. — Сейчас нам нужно как можно быстрее и эффективнее вакцинировать наших людей теми вакцинами, которые уже прошли клинические испытания и подтвердили свою высокую эффективность".
Пока, несмотря на все усилия властей, число привитых в Украине остается крайне низким: получили обе дозы вакцины менее трети всего взрослого населения. Тем не менее, многие горожане готовы вместо укола от коронавируса съесть таблетку или применить спрей. Получат ли львовские ученые финансовую поддержку от украинского государства, если препарат пройдет необходимое тестирование – пока не известно: это зависит от решения правительства Украины.
Коронавирусная инфекция COVID-19
Коронавирус SARS-CoV-2, ранее известный как 2019-nCoV, обнаружили в Китае в конце 2019 года.
Он вызывает заболевания COVID-19. В некоторых случаях течение болезни легкое, в других – с симптомами простуды и гриппа, в том числе с высокой температурой и кашлем. Это может перерасти в пневмонию, которая может быть смертельной. Большинство больных выздоравливает; умирают преимущественно люди с ослабленной иммунной системой, в частности пожилые.
11 марта 2020 года Всемирная организация здравоохранения признала вспышку заболевания, вызываемого новым коронавирусом, пандемией.

FACEBOOK КОММЕНТАРИИ: